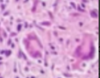

Histopathology 18 - Immune disorders Flashcards
(33 cards)
What does SOAP BRAIN MD staind for?
SLE features
Serositis
Oral ulcers
Arthritis
Photosensitive
Blood (pancytopoenia)
Renal (proteinuria)
ANA
Immunological (anti-dsDNA)
Neurological (psych, seizures)
Malar rash
Discoid rash
Which autoantibodies are present in SLE?
ANA - anti-dsDNa, anti-Sm, anti-histone
Which autoantibody is most specific for SLE
anti-dsDNA
anti-histone also raised in drug related - e.g. hydralazine
What method is used to measure anti-dsDNA?
Incubate patient’s serum with Crithidia Luciliae (a protozoa)
also ELISA
What is titre and how do you interpret it?
titre - dilution value (e.g. 1:10) - highest dilution at which you can still see fluorescence is titre (i.e. 1:1000 > 1:40)
What will skin histology show in SLE?
Lymphocytic infiltration of dermis
Vacuolisation (dissolution of cells) of basal epidermis
Extravasation of RBCs → rash
Immunofluorescence (antibody to IgG) will show immune complex deposition at epidermis-dermis junction

What will renal histology show in SLE?
Glomerular capillaries thick (“wire-loop”) due to immune complexes in BM
immunofluorescence can be used to visualise the immune complex deposition (electron microscopy will also show dark areas of immune complex deposition)
What type of endocarditis is associated with SLE?
Libman-Sacks, non infective
s/s: emboli, heart failure or murmurs
Vegetations = lymphocytes, neutrophils, fibrin strands etc.
What is the localised form of scleroderma called?
morphoea in skin
Which antibodies are involved in diffuse vs limited cutaneous systemic sclerosis (scleroderma)?
diffuse - Anti-topoisomerase (anti-Scl70) - nucleolar pattern
limited - anti-centromere

What are the differences between diffuse versus limited systemic sclerosis?
diffuse - involves trunk
limited - no trunk involvement
Recall the features of CREST syndrome
associated with LIMITED systemic sclerosis

What are the skin histological features of scleroderma?
↑ collagen → ↓ skin elasticity
N.B. difficulty swallowing and stomach dysmotility due to excess collagen within lining → reduced elasticity
What are the vascular histological features of scleroderma ?
renal crisis (v high BP)
intimal proliferation → onion skin
Lumen effectively obliterated and some small thrombi form

What does a speckled pattern of ANA on immunofluorescence suggest?
mixed connective tissue disease
What are the clinical features of dermatomyositis?
proximal muscle pain and weakness
High CK
Gottron’s papules (erythematous rash over the knuckles)

Recall the clinical features of sarcoidosis
Joints
Skin (lupus pernio, erythema nodosum)
Lungs (fibrosis, lymphocytosis (increased CD4+ cells in BAL)
Lymphadenopathy
Heart (any layer: pericardium, myocardium, endocardium)
Eyes (uveitis, keratoconjunctivitis)
CNS (meningitis, cranial nerve lesions)
Liver (hepatitis, cirrhosis, cholestasis)
Parotids (bilateral enlargement)

What is the histological features pf sarcoidosis?
non-caseating granulomata (ball of activated macrophages);
composed of:
Histiocytes (epithelioid cells)
Multinucleated giant cells of Langerhans (peripheral nuclei) – fused macrophages → horseshoe appearance
Lymphocytes
What are the biochemical features of sarcoidosis ?
Hypergammaglobulinaemia
↑ ACE
Hypercalcaemia (vitamin D hydroxylation (1a-hydroxylase) by activated macrophages)
What are some examples of small vessel vasculitis?
- IgA vasculitis (HSP)
- anti-GBM
- microscopic polyangitis
- granulomatosis with polyangitis (Wegner’s)
- eosinophilic granulomatosis with polyangitis (Churg Strauss)
Recall two examples of medium vessel vasculitis
Polyarteritis Nodosa
Kawasaki
Recall two examples of large vessel vasculitis
Takayasu
Giant cell
What rash is characteristic of vasculitis?
palpable purpuric rash characteristic of vasculitis
Nail fold infarcts are also a feature of vasculitis